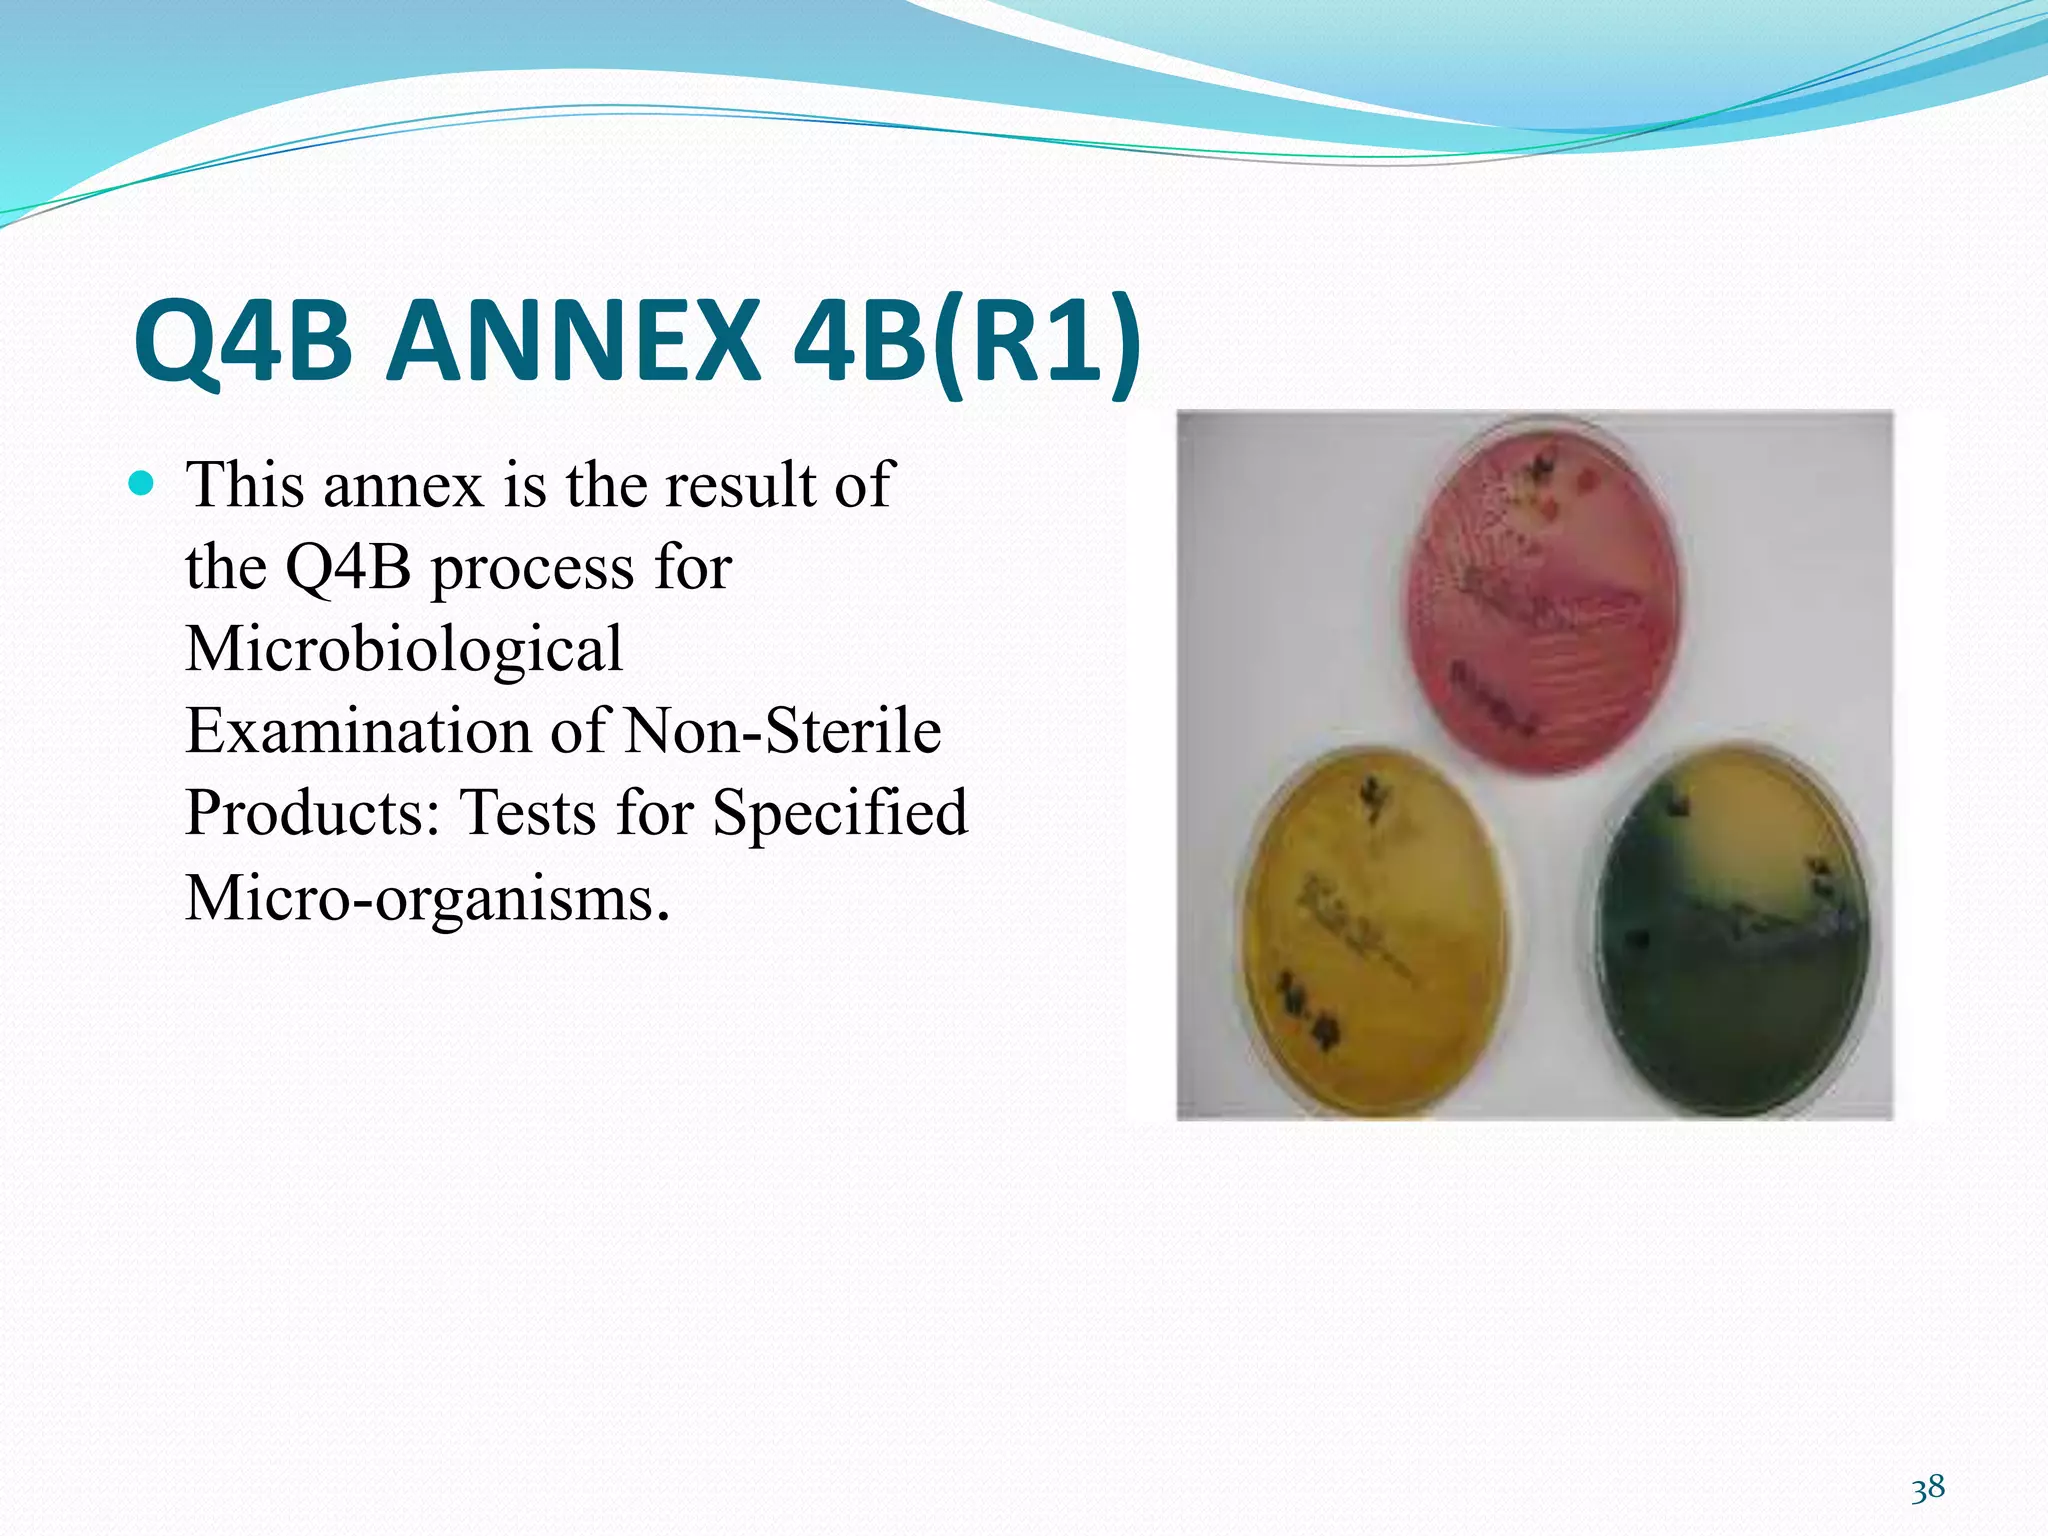
Q4B ANNEX 4B(R1)
 This annex is the result of
the Q4B process for
Microbiological
Examination of Non-Sterile
Products: Tests for Specified
Micro-organisms.
38

The document discusses guidelines from the International Conference on Harmonization (ICH) related to quality and specifications of pharmaceutical products. It describes several ICH Q guidelines including Q1 on stability testing, Q2 on analytical method validation, Q3 on impurities, Q4 on pharmacopoeial harmonization, and Q5 on biotechnological/biological products. Key points covered include requirements for stability testing protocols, validation of analytical methods, identification and qualification of impurities, harmonization of pharmacopoeial standards, and viral safety evaluation of cell-derived biopharmaceuticals.